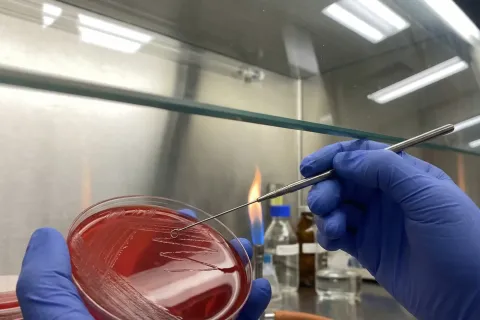
制药厂QC微生物限度与无菌检查实验室净化工程（GMP标准）

纺织服装与纸张物理性能检测标准恒温恒湿实验室
严格遵循GB/T 6529标准建设的标准大气实验室(温度20±2℃,湿度65±4%)。重点解决了加湿不均与冬季静电问题,为织物强力、色牢度测试提供了稳定可靠的数据基础。
项目背景与难点: 纺织品、纸张和纸板的物理性能(如拉伸强度、撕裂度、耐折度)与环境湿度密切相关。GB/T 6529标准规定了“标准大气”环境:温度20±2℃,相对湿度65±4%。项目的难点在于:高湿度(65%)的维持。特别是在干燥的冬季,普通加湿器难以达到该湿度,且容易产生“白粉”污染样品,或者因加湿过量导致天花板结露滴水。
工程技术详解(解决方案):
- 电极式洁净蒸汽加湿: 我们选用了电极式蒸汽加湿器,通过电流电解水产生纯净蒸汽。相比超声波喷雾,蒸汽加湿不产生钙镁离子粉尘(白粉),不会污染深色织物样品,且加湿效率高,响应速度快,能迅速将湿度拉升至65%并维持稳定。
- 防冷桥与防结露设计: 在高湿度环境下,若送风口温度过低,极易产生冷凝水。我们在风管外包裹了橡塑保温棉,并对送风百叶进行了防结露处理。同时,经过计算合理设定了送风温度,确保送风含湿量与室内露点匹配,彻底杜绝了“室内下雨”的风险。
- 多点温湿度监控: 在实验室的四个角落及中心区域布置了5个温湿度传感器,数据汇总至中央控制屏。系统根据平均值进行调节,确保无论样品放置在房间哪个角落,所处的环境条件都是一致的,保证了检测数据的重复性与可比性。
项目交付与成效: 实验室建成后,客户顺利通过了CNAS及CMA资质认定。稳定的高湿环境不仅消除了冬季静电干扰,更使得纸张和织物测试数据的准确性大幅提升,帮助客户在激烈的市场检测业务竞争中脱颖而出。
![[广州]净化工程_模块化洁净室设计施工厂家](https://img.wuchenshi.com/wp-content/uploads/2025/12/2025121716031130.svg)